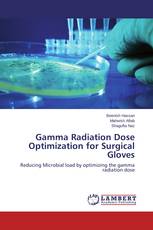
Gamma Radiation Dose Optimization for Surgical Gloves

Enhancing Vocabulary Recall through the Power of Fantasy
Sharareh Ebrahimi - ISBN: 978-3-659-69963-4
Gamma Radiation Dose Optimization for Surgical Gloves
Reducing Microbial load by optimizing the gamma radiation dose
Beenish Hassan, Mahwish Aftab, Shagufta Naz - ISBN: 978-3-659-69951-1
The Keys to Success
Coaching Styles of Professional Championship Teams
Amy McRae - ISBN: 978-3-659-49912-8
Bartonella species in fleas from Palestine
Prevalence and genetic diversity
Ahmed Rishiq, Abedelmajeed Nasereddin, Ziad Abdeen - ISBN: 978-3-659-53343-3
Homeschooling as an Educative Journey
Responding to Learner's Realities
Rachel Edita O. Roxas - ISBN: 978-3-659-69780-7
Автоматизированные системы контроля и управления дорожным движением
Владимир Мышляев - ISBN: 978-3-659-69989-4
PC/PMMA/PS Nano composite with Pristine and Functionalized MWCNTs
Khakemin Khan, Rasool Kamal - ISBN: 978-3-659-69277-2
Г.Дзасохов – видный просветитель и педагог северокавказских народов
Надежда Блейх - ISBN: 978-3-659-63089-7
Особенности эксплуатации тракторов с газобаллонным оборудованием
Ильдар Дагиевич Нигматулин, Виктор Владимирович Володин, Борис Павлович Загородских - ISBN: 978-3-659-38204-8